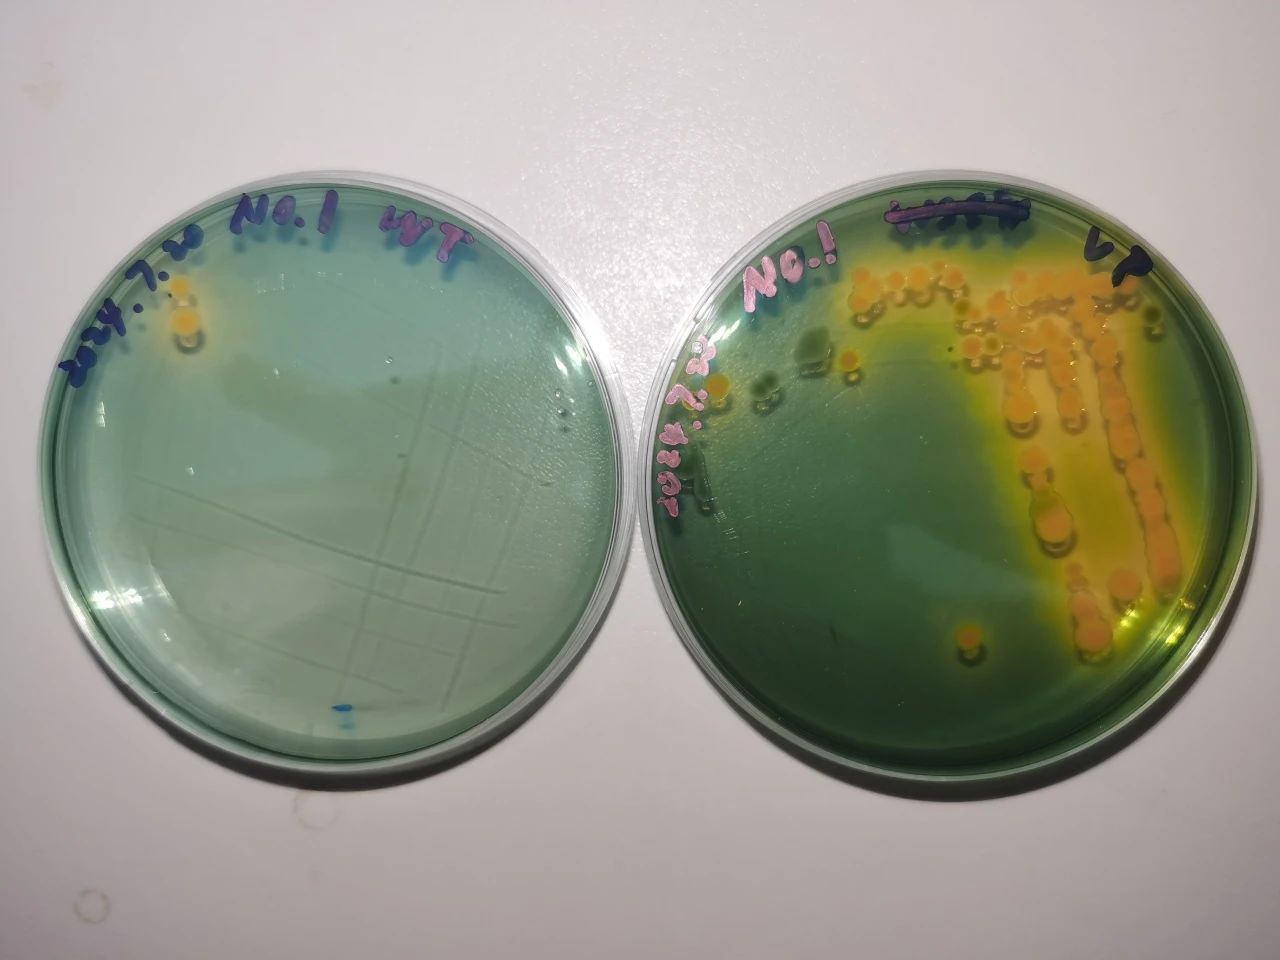

水生生产实习丨从深水到水生,在实习中习识
实习前言
纸上得来终觉浅,绝知此事要躬行。尽管鱼虾蟹在如今的家常餐桌上已经十分常见,尽管中国已成为最大的水产养殖国家,我们却很少有人了解水产行业的发展历程与各种野生动物的保护现状。
保持对深海奥秘的探索兴趣,带着老师提出的两个问题,我们在老师的带领下,从广州出发,途径珠海,一路南下来到湛江,踏上了探寻答案的深海之旅。
广州
南沙湿地公园
广州水生野生动物保护基地
广州市诚一水产养殖有限公司
华农南沙渔业研究所
珠海
“珠海云”无人科考船
南方海洋实验室
珠海粤顺水产养殖公司
珠海庆隆农业科技有限公司
湛江
国美、国联水产公司
国家863计划项目海水养殖种子工程南方基地
恒兴集团
寸金桥公园
东海岛党群服务中心
1. 参观学习与讲座培训
1. 南沙湿地公园
南沙湿地公园地处广州最南端的珠江入海口西岸,总面积约一万亩,是候鸟的重要迁徙路线之一。其良好的自然生态环境为周边地区起着防风消浪、涵养水土、调节气候等重要作用,有“广州之肾”的美称。
我们随湿地公园观光船沿水域游行,一路上见到了夜鹭、牛背鹭、白鹭等常见湿地鸟类,也近距离观察到了在课堂上经常被提起的红树林生态系统。在这次参观过程中,我们受益匪浅,切实感受到了保护生态系统的重要性,也意识到人与自然和谐相处,才能更好地保护好我们共同的家园——地球。习总书记提出的“绿水青山就是金山银山”的发展理念也需要我们一直努力践行下去。

2. 广州市水生野生动物保护基地
接下来我们参观了广州市水生野生动物保护基地。在这里我们聆听了三个关于水生野生动物的讲座,深刻地揭示了这些生物面临的困境。由于自然环境遭受人为的破坏和退化,它们的生存领域正逐渐缩小。目前,迫切需要加大科普教育和宣传的力度,以提升公众对保护水生野生动物重要性的认识。




3. “珠海云”无人科考船
“科学技术是第一生产力”,水生生物的保护也离不开现代科学技术发展的支持。在阳光灿烂、碧波万顷的蓝海之滨,我们登上了“珠海云”科考船。
“珠海云”是全球首艘智能型无人系统母船,具有远程遥控和开阔水域自主航行功能,船体设计贯彻“未来感”、“无人系统保障”、“绿色智能”三大理念。“珠海云”号的建成展现了我国船舶建造技术的发展,彰显了大国实力。
船长带领我们参观了船体内的主要构造,我们参观了船员的卧室、会议室和休息室,其条件之优越,令同学们十分羡慕。也希望“珠海云”的投入使用,能为我国海洋科考注入新鲜血液,引领我国在迈向海洋强国的道路上走得越来越稳健。


4. 南方海洋实验室
南方海洋实验室是由珠海市人民政府举办,发卡平台
牵头建设和管理的第二批广东省实验室之一。其目标是建设面向科技前沿、具有国际领先水平的海洋创新基础平台,构筑世界一流的海洋人才高地,打造创新型、引领型、突破型的大型综合性海洋研究和应用基地。
在这里,我们不仅参观了南海四基观测系统和海洋立体观测网,也通过幻灯片观看到了“一鲸落,万物生”的震撼场面。此外,海洋生物资源库的先进也令我们惊叹科技的伟大。




2.养殖一线——
水产产业链的追根溯源
01
粤顺、庆隆养殖场
——水产工作者的真实诉求
为了深入了解水产行业,我们的生产实习参观从基层起始,倾听水产工作者的真实诉求。到达珠海粤顺水产养殖公司的养殖场,大片的鱼塘平铺眼前,我们看见了水产养殖的一线场景。在那里,老师告诉我们养殖者的基本诉求:低成本和高回报。养殖的成本来源于种苗、饲料、塘租;而当今的经济形势导致鱼粉价格上涨,鱼苗质量下降,塘租升高,进而影响了饲料配比和养殖密度,最终致使海鲈病害增加。养殖场内也有海水鱼病毒防控实验室。实验室内部设施虽然简陋,但是实用,再次体现了一线养殖对资源利用最大化的诉求。

粤顺养殖场鱼塘

海水鱼病毒防控实验室

实验室内部
同样身为小型水产养殖公司的还有珠海庆隆农业科技有限公司。我们参观了该公司的罗氏沼虾养殖场。在养殖塘中,种植了许多茜草,为罗氏沼虾提供住所和食物。打捞上来的罗氏沼虾成虾个头很大,据养殖员所说:他们养殖的罗氏沼虾3个月便可达到13尾一斤。在参观和交流中,我们初窥水产养殖产业链,发现并了解到一线养殖的关键,在于种苗、饲料和动物保健品。

庆隆养殖场


罗氏沼虾


合影留念
02
诚一、华农南沙渔业研究所
——水产“智”造
较之粤顺和庆隆养殖场,广州市诚一水产养殖有限公司更具规模,对于一线养殖的难题,给出了他们独到的解决方案。讲座上,有关诚一公司 “1+6生态养殖模式”和“345生态养殖体系”的介绍令人印象深刻。所谓“1+6生态养殖模式”是以草鱼为主品种,搭配鲢、鳙、鲫、鲮、黄颡鱼和青鱼等品种的混合养殖,将主养鱼类草鱼的代谢产物作为其它生物的营养物质加以利用,变废为宝;“345生态养殖体系”则分别为3级分级养殖模式、4化养殖管理和5S鲜鲩产品标准。更令人感到惊奇的是诚一公司主推的智慧渔业:采用智能投喂机实时调整投喂量和投喂时间,节约成本;推广养殖数字化、智能化、精细化和数据化,极大程度节省了成本并提高了效率。


诚一水产
华农南沙渔业研究所则将研究重点放在一线养殖的种苗问题上。研究所围绕南沙渔业产业高质量发展实际需求,设立南沙青蟹、小虎麻虾、黄鳍鲷、智慧渔业与设施养殖、水产种质资源与环境在内的8个科研项目,配备200亩左右“华农南沙渔业高科技园”,打造“建在塘头的渔业研究院”。华农南沙渔业研究所聚焦育种痛点,其研究成果将极大缓解南沙、珠三角乃至粤港澳大湾区的青蟹和小虎麻虾种苗不足问题,为养殖户提供优质种苗。

华农南沙研究所及其鱼塘
03
国美、国联水产公司
——水产品加工和销售现状
真实的水产品生产线样貌在踏进国联和国美水产公司那一刻便映入眼帘。一条条罗非鱼和黑鱼在刀手手中顷刻间化作鱼片,再经过剔骨、称重分选、清洗、上浆和真空包装等一系列流程,包装好的鲜鱼片便可出厂进入市场。国联水产拥有全国最大的对虾生产线,有全自动和半自动剥虾线以对应不同需求(开背、去头去尾等)。在那里,国联水产的工作人员为我们介绍了水产品销售现状:较之当今的出口形势,以往美元兑人民币汇率较低时,水产品可大量出口至国外,为外贸总量做出巨大贡献,中国也在2022年逐渐发展成为全球第一大水产品贸易国,第一大出口国和第二大进口国。但也正是在那一年,水产品贸易由多年顺差首次转为逆差。当前水产品出口面临的主要问题在于:1)生产和技术成本逐渐劣势于厄瓜多尔等国;2)出口高度依赖美国市场,中美经贸摩擦导致出口规模加速萎缩;3)对外的ODM生产模式,缺乏国外的自主品牌;4)出口面临严峻的技术性贸易壁垒。正是外贸的困难,水产品销售方向逐渐转向内销,国联水产也在2018年开始生产预制菜。在经济形势的浪潮下,往后几年更多的预制菜将会涌入市场。




生产车间


国联集团预制菜产品
04
“863”育种基地、恒兴基团
——水产的全产业链
位于广东省湛江市东海岛的国家863计划项目海水养殖种子工程南方基地(以下简称“863基地”),培育出了“中兴1号”、“中兴2号”凡纳滨对虾(南美白对虾)品种。该品种具有高抗弧菌和高产的优良性状,解决了种虾的“卡脖子”问题。在863基地,领导为我们介绍了863基地的研发工作及研发成果。除了南美白对虾,基地还开展了红螯螯虾、巴沙鱼、大黄鱼等其他品种的育种研发工作。此外,863基地也积极探寻优质养殖模式:以浓缩藻定向培藻水质。我们还聆听了基地研究员胡一丞有关南美白对虾的生理特征、人工育苗技术方法和步骤,以及育种技术发展现状的介绍。基地研究员尹斌则为我们详细介绍了 “中兴2号”种苗的选育原理及过程:研究发现凡纳滨对虾的LvIRF 基因启动子区域存在一个以(CT)为重复基元的SSR分子标记,具有多态性,并且决定了LvIRF基因的表达量。而该基因的表达量与对虾的抗病毒和抗菌能力相关,当IRF-(CT)n 重复数多,LvIRF 表达量低,对虾抗弧菌性状强。基于此理论依据,后续经过群体挑选、杂交、群体内杂交等多步选育,诞生了凡纳滨对虾“中兴2号”。



863基地由恒兴集团承担建设,也为恒兴集团提供了育种技术支持。而恒兴集团作为大型水产企业,在水产产业链的其他环节也同样出色,为“打造从塘头到餐桌的水产食品产业链”而努力。在了解恒兴集团发卡平台之余,我们还走进了集团的动保、饲料检测和研发中心,参观了研究中心的实验室。由恒兴集团研发的动保产品种类多样,涵盖了水产养殖的多方面。此外,恒兴集团在饲料产业方面也具备一定规模,其饲料种类覆盖众多养殖品种,出口多个国家。在公司的饲料生产车间,我们了解到饲料生产的流程,参观了饲料生产的设备,也增长了见识。在恒兴集团的参观过程中,我们看到了大企业的社会担当,也逐步看清水产产业链的全貌,能将水产品从育种到包装生产的各个环节串联起来,从中获得了新的体会,刷新了以往对于水产品生产的认知。这一系列的参观也让我们真正地深入到一线,看到了公司生产和实验室研发的差别,在丰富眼界的同时,启发了科研思路。



3.自己动手——
“863”基地生产实训
1南美白对虾解剖及病理检测
南美白对虾是十足目对虾科对虾属动物,又称白皮虾、白对虾,主要分布在美洲太平洋沿岸,是厄瓜多尔等美洲国家主要养殖品种,中国黄海、渤海一带也有养殖。作为养殖界高度关注的高产养殖虾种,南美白对虾具有较高的经济价值和营养价值,由于壳薄体肥,性温、味甘,深受大众喜欢,成为世界三大主要对虾养殖品种之一。 中国1988年自美国引进此虾,现已在全国各地推广养殖,实现了淡水驯化及养殖,并呈现出取代罗氏沼虾养殖的趋势,成为水产养殖业的重中之重。在863基地,我们首先进行了南美白对虾的解剖、病理检测等实验。

2大黄鱼的电子芯片标记及形态观察与解剖
大黄鱼是鲈形目石首鱼科黄鱼属鱼类,别名黄花鱼、黄鱼、大鲜。大黄鱼分布于西北太平洋,在中国沿海均有分布。栖息于水深60米以内的软泥或泥沙底质海域,喜集群。食性广,主要以虾、蟹等甲壳动物和小鱼为食。春季繁殖,通常在河口、内湾、岛屿附近产卵。大黄鱼为名贵的可食用经济鱼类,为中国传统四大海产渔业种类之一。由于过度捕捞,种群数量下降,目前已被世界自然保护联盟(IUCN)列为极危(CR)物种。在山东、福建、广东、台湾等地有人工养殖及增殖放流。



大黄鱼
3水质检测及藻类观察
水质及水体内生物在鱼类、虾类等水产品的养殖过程中是极其重要的一环,因此,检测水质及藻类对水质评价具有重要意义。





4.思政教育及党政学习
01
1961年,郭沫若到湛江题诗“一寸河山一寸金”,寸金桥桥名含中华国土寸土寸金不容外敌侵占之意,以纪念1898年湛江人民抗法斗争的英雄事迹。
游览寸金桥公园,不仅享受自然风光,也了解国家国防安全知识,还可以通过参观公园内的烈士纪念碑,缅怀那些为国家独立和民族解放做出巨大牺牲的先烈们。勿忘国耻,振兴中华。


寸金桥公园
02
在东海岛党群服务中心,通过学习党史,重温党的历史上的重大事件,了解中国共产党在湛江的历史故事,我们可以更好地理解党的伟大、光荣和正确,增强对党的认同感和归属感,为实现中华民族的伟大复兴贡献自己的力量。同时,了解湛江本地的民俗风俗等活动,感受当地风土人情。对湛江当地的经济发展现状及未来规划进行简要了解,充分体会国家政策与当地经济发展的紧密联系。



东海岛党群服务中心
5.“两个问题”的回答
01
揭秘:为什么“青草鲢鳙”是四大家鱼?
四大家鱼分别是青鱼、草鱼、鳙鱼、鲢鱼,简称青草鲢鳙。它们分别有着各种各样的别称。草鱼体型修长,青鱼与草鱼在外形上相似,但是鳞片和鱼鳍都带灰黑色,鳞片也比较粗大。鲢鱼的头小体侧扁,鳞细腹肥,体色呈银白,而鳙鱼头部较大,鳞片细小,较鲢鱼而言不太活泼。

首先需要考虑大众的选择。比起产业、生态等方面,大众更多关注鱼的口感和营养价值。四大家鱼在达到基本的食品标准基础上,能够同时满足这两点。以草鱼为例,肉质鲜美,同时具有性温、味甘,平肝、祛风、活痹、截疟、暖胃的作用。并含有丰富的不饱和脂肪酸,对血液循环和心血管患者有益。
其次,我国漫长的传统渔业和养殖业历史证明,青草鲢鳙具有良好的养殖效益。从生物学(习性)角度分析,它们生长快、适应性强:均具有较高的生长速度和较强的适应能力,能在多种水域环境中生存和繁殖。四大家鱼的食性不同,因此,能够充分利用水体中的食物资源,提高饵料的利用率,增加鱼的产量。从生态学角度分析,四大家鱼占据不同的生态位,在水体中的不同层次活动,减少了相互间的竞争,提高了水体的生态稳定性。鲢鱼主要在水域的上层活动,吃绿藻等浮游植物;鳙鱼栖息在水域的中上层,以原生动物、水蚤等浮游动物为食;草鱼生活在水域的中下层,以水草为食物;青鱼栖息在水域的底层,以螺蛳、蚬和蚌等软体动物为食。通过混养青草鲢鳙,不仅具有高效的资源保护利用率,还能有效控制水体中的藻类、浮游动物、底栖动物等生物的数量,维持水体的生态平衡和生物多样性。

四大家鱼生态位
与之对比,常见常被食用的鲤鱼、鲫鱼不是四大家鱼,其中的原因复杂,包括文化历史、生物学特性和生态适应性、养殖技术和效率、经济价值与市场需求、国家政策和技术支持等影响因素。比如,唐代皇帝姓李,鲤与“李”音相近,为避讳“鲤”字,鲤鱼不被食用。此外,鲤鱼和鲫鱼在繁殖上颇有天赋。生长速度较慢,体型较小,从商业养殖的角度看,产量不及四大家鱼。尽管鲤鱼和鲫鱼在中国部分地区具有较高的消费率,但在全国市场上,它们的经济价值和消费需求不及四大家鱼。也正因如此,政府和科研机构往往更倾向于投资于四大家鱼的育种和病害控制研究,四大家鱼在养殖技术上有显著的优势。
02
展望:AI在水产行业的应用?
AI(Artificial Intelligence)即人工智能,是新一轮科技革命和产业变革的重要驱动力量,是研究、开发用于模拟、延伸和扩展人的智能的理论、方法、技术及应用系统的一门新的技术科学。AI大模型存储大量的参数,构建深度神经网络架构,具备强大的学习、预测和推理能力,在各个领域都有应用。
AI在推动水产产业发展方面也起着至关重要的作用。如对养殖环境进行监测并及时预警,通过水质监测器实时收集水温、pH值、溶解氧浓度等数据,判断养殖环境是否适合生物生长,发现异常时向管理人员发送警报;根据鱼虾的摄食行为识别算法,分析摄食状态,判断投喂时间、投喂量和投喂速度是否合适,实现智能饲料喂养,提高饲料转化率;进行病害监测预警与健康状况诊断,分析养殖鱼虾的行为、状态等数据,结合水产病害大数据库,判断其是否具有发病风险,并智能判断疾病种类,给出防治建议,避免病害大规模爆发;通过视频监测和图像处理技术,感知鱼群的生长状况;通过分析水质和气象数据,预测养殖水域的水质变化,确保渔业生产的安全和稳定等。此外,AI能够实现对水产品品质的快速检测与分类,提升市场竞争力,并基于大数据的市场分析工具帮助企业洞察市场趋势,精准定位消费者需求,制定更有效的销售策略,指导产业中的科学决策。本次生产实习中,目前水产行业面临一些问题直观地展现出来,AI或许就是解决之道。

智慧水产养殖示意图
(文中图片均来源于网络)
实习总结
快乐的时光总是短暂的。通过十几天的生产实习,我们收获颇丰。平时坐在宽敞明亮的教室里,我们学习了许多课本上的理论知识。然而,真正接触水产养殖行业的工作现状以及各种水生生物实验,才让我们对其有了更加深刻的理解。经历了酷暑暴晒和狂风暴雨,才让我们明白,真正的学习不应当只来自于课本,而应该将学到的知识合理运用到生活与生产中,让生活更加美好。
有如此精彩的生产实习生活离不开学院与老师给我们提供的珍贵条件,在此向何建国老师、翁少萍老师、孙彩云老师、谢俊锋老师以及高杰师兄和刘怡萱师姐表示衷心的感谢!同时也要感谢热情迎接我们的水产公司及基地员工。
希望我国水产养殖业蓬勃发展,蒸蒸日上;希望我国向海图强,奏响海洋强国之歌!


